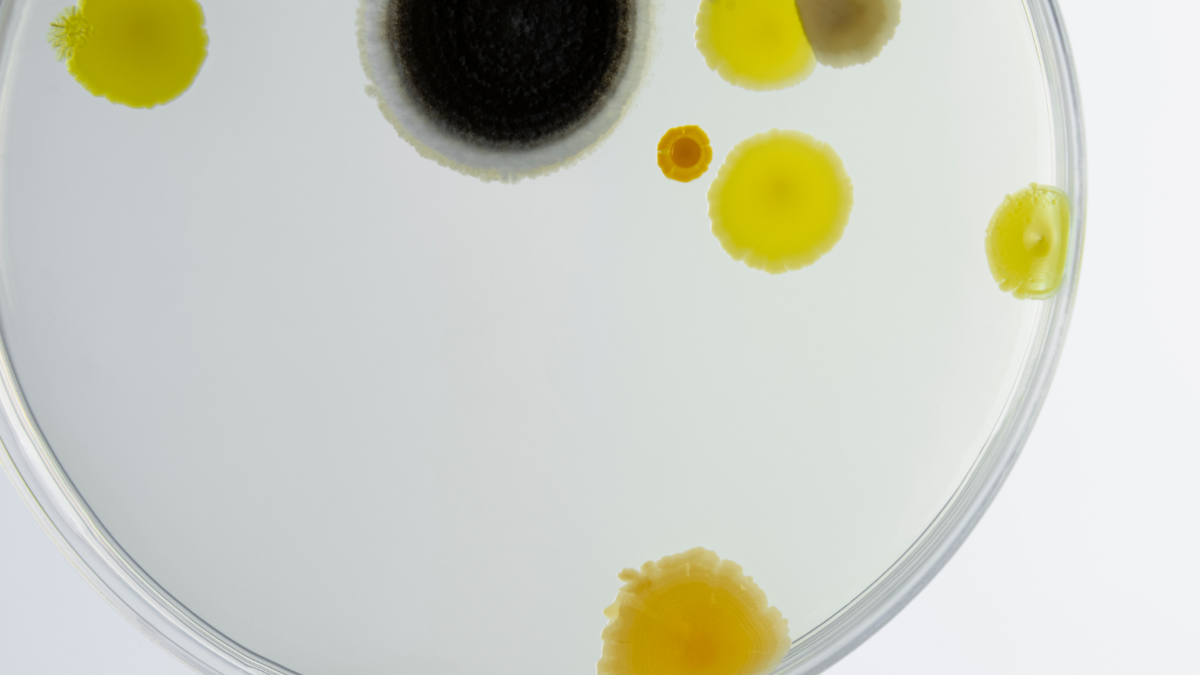
Photo of a round petri dish containing cell cultures

Student Q&A: Biomedical Engineering Graduate on Co-op Experience in Pharmaceutical R&D
Debraj Das ’23 applied his Stevens education to a co-op at a major pharmaceutical company by investigating a drug’s potency on human cells, with the hope of treating autoimmune disorders
From May to December 2022, Stevens Institute of Technology biomedical engineering graduate student Debraj Das ’23 completed a research and development co-op at Janssen Pharmaceutical Companies of Johnson & Johnson in Malvern, Pennsylvania. During his time there, he worked on testing the effectiveness of therapeutic drugs to treat autoimmune disorders.
Das joined Smera Venkateswar ’26, a first-year biomedical engineering student, to talk about the experience.
Venkateswar: What was the goal of your work in research and development?
Das: My role was to conduct different types of tests to measure the effects of Nipocalimab, a drug used for immune diseases and diabetes. We were trying to determine if a specific protein and antibody found in the body would attach to the drug or not. Based on my findings, we could go forward with drug formulation development, manufacturing and building a pharmacy manual.
V: What did a typical day look like for you?
D: Since my focus was on testing, I worked in the lab every day, conducting bioassay tests, which measure the potency of a drug by looking at the effect on cells. I was mainly looking at how the drug would react with the body. Initially, we conducted these tests on human embryonic kidney (HEK) cells, then moved on to Chinese hamster ovarian (CHO-K1) cells. I’ve never worked on this kind of cell culturing before, so I learned so much from working in bioassay method development.
V: What was your favorite part of the experience?
D: My favorite part of the co-op was being able to use a variety of new high-tech lab equipment! I was introduced to tools and processes that I had only ever read about before, and being able to use them for research was a dream come true. Through my work, I learned the specific processes by which a drug is developed and transformed into a product at big companies like Janssen.
On a more personal front, I really connected with my team. From day one, everyone was very supportive, and I always felt like the whole team was there to motivate me and help me in any way possible. I never felt left out.
V: How would you say Stevens prepared you for this co-op?
D: In my first couple semesters at Stevens, we were assigned a lot of homework, tests, quizzes, and presentations. I had to learn time management, which was difficult with everything I was juggling as an international student. It actually went both ways — I was able to learn from my co-op and apply it back to Stevens as well. Since I had to get out of my comfort zone and talk in front of the team during meetings, my presentation skills improved greatly, and I feel more comfortable and confident presenting this semester.
V: What advice do you have for students starting co-ops?
D: Be confident and be assertive! When you start your first internship, it’s easy to think that because you’re less experienced, you can’t contribute as much. [But] you were selected for a reason — talk to your team and express what you’re thinking. Don’t be afraid to put yourself out there.
Janssen is a leading pharmaceutical company. Their work in developing medicines has benefited more than 150 countries through researching areas of medicine, including infectious diseases and vaccines, neuroscience, and oncology. Learn more about their work, or learn more on industry education at Stevens.